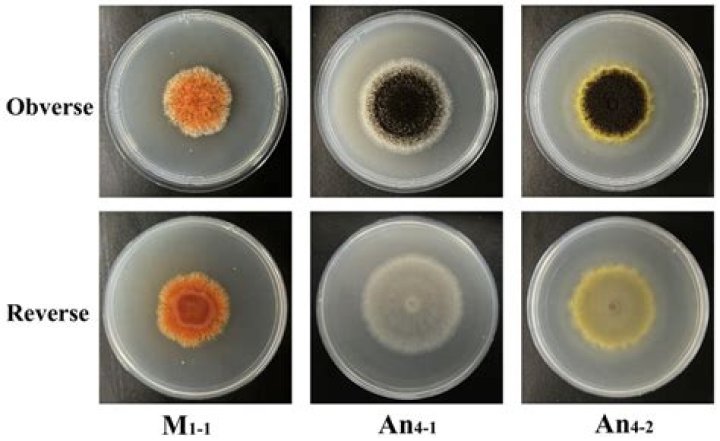

Where is sentinel lymph node?

Daniel Davis
Updated on February 21, 2026
Sentinel nodes are simply the first nodes draining a cancerous region. For breast cancer, they are usually located in the armpit. That's why healthcare providers test the sentinel nodes to see if cancer has spread beyond the original tumor.
How many sentinel lymph nodes are there?
In most cases, there are one to five sentinel nodes, and all are removed. The sentinel nodes are sent to a pathologist to examine under a microscope for signs of cancer. In some cases, sentinel node biopsy is done at the same time as surgery to remove the cancer.
Can you feel a sentinel lymph nodes?
You may feel scar tissue along your incision as you continue to heal. It will feel hard. This is common and will soften over the next several months. You may have a bluish-green stain near your incision from the blue dye that was used to find your sentinel node(s).
How painful is sentinel lymph node biopsy?
After a sentinel node biopsy, many people have no side effects. Some people have pain or bruising at the cut (incision) and feel tired. Your breast and underarm area may be slightly swollen. This may last a few days.
What is the difference between sentinel and axillary lymph nodes?
Axillary dissection removes more nodes and disrupts more of the normal tissue in the underarm area than a sentinel node biopsy. So, it's more likely to affect arm function and more likely to cause lymphedema. For this reason, sentinel node biopsy is the preferred method to check the axillary lymph nodes.
Sentinel Lymph Node Biopsy (SLNB) for Breast Cancer
42 related questions foundWhat happens if sentinel node is positive?
If the biopsy is positive, it means that cancer cells have been found in the sentinel lymph node. The surgeon may then proceed with axillary lymph node dissection—a more invasive procedure that involves removing more lymph nodes. For certain types of cancer, biopsy results are also used to determine the cancer stage.
How many sentinel lymph nodes are in your armpit?
The number of axillary lymph nodes can vary from person to person, ranging from five nodes to more than 30. After a breast cancer diagnosis, a doctor will often check whether cancer cells have spread to the axillary lymph nodes.
Can a surgeon tell if lymph node is cancerous?
Lymph nodes deep in the body cannot be felt or seen. So doctors may use scans or other imaging tests to look for enlarged nodes that are deep in the body. Often, enlarged lymph nodes near a cancer are assumed to contain cancer. The only way to know whether there is cancer in a lymph node is to do a biopsy.
How long does it take to get the results of a sentinel node biopsy?
Depending on your surgeon, you may find out the results of the frozen lymph node quick look immediately after surgery. The final results of the examination of your sentinel lymph node will usually be available in five working days. Your surgeon will discuss these results with you.
How long do sentinel lymph node biopsy results take?
It takes 1 or 2 weeks to get the results. Your doctor will usually discuss them with you at your next clinic appointment. Waiting for test results can be worrying. You might have contact details for a specialist cancer nurse.
How do I know if I have sentinel nodes?
To identify the sentinel lymph node(s), the surgeon injects a radioactive substance, blue dye, or both near the tumor. The surgeon then uses a probe to find the sentinel lymph node(s) containing the radioactive substance or looks for the lymph node(s) stained with dye.
When should a sentinel lymph node be biopsied?
Sentinel lymph node biopsy can be done before or after the tumor is removed. Findings from the Multicenter Selective Lymphadenectomy Trial II (MSLT-II) also confirmed the safety of SLNB in people with melanoma with positive sentinel lymph nodes and no clinical evidence of other lymph node involvement.
What are the side effects of having lymph nodes removed?
Other side effects of lymph node removal can include:- infection.
- a build up of fluid at the site you had surgery (seroma)
- problems with your wound healing.
- numbness, tingling or pain in the area - this is due to nerve injury.
- blood clots - more common after removal of lymph nodes in the groin area.
- scarring.
What is the difference between a sentinel node from other lymph nodes?
Sentinel nodes are the first lymph nodes where cancer cells might spread from a tumor. Lymph nodes are small organs that “filter” fluid in the body and help protect you from illness. The word “sentinel” means a guard or someone keeping watch.
Do lymph nodes grow back after removal?
The surgery reconnects the system. “As the reconnected lymph nodes start working, they send signals to the body to start recreating channels that have not been working,” Dr. Manrique says. “The procedure sets in motion the regeneration of the lymphatic system and ultimately the circulation of the lymphatic fluid.
Do I need chemo if lymph nodes are clear?
Chemotherapy is almost always recommended if there is cancer in the lymph nodes, regardless of tumor size or menopausal status.
What percentage of lymph node biopsies are malignant?
Overall, 34% (117 of 342) of biopsies showed malignant disease, either lymphoreticular (19%; 64 of 342) or metastatic (15%; 53 of 342), and 15% (52 of 342) tuberculous lymphadenitis.
Can you drive after a lymph node biopsy?
If more than 6 lymph nodes were removed, your surgeon will explain exercises at your post-op check. Most patients can drive within one week after surgery, as long as you have not used any narcotic pain medication for 48 hours.
How accurate is sentinel node biopsy?
Accuracy of sentinel node biopsy. Introduction: Sentinel node biopsy is the main way to assess lymph node status. If there's cancer in the lymph nodes, sentinel node biopsy will find it over 90 percent of the time [1].
What are the warning signs of lymphoma?
Signs and symptoms of lymphoma may include:- Painless swelling of lymph nodes in your neck, armpits or groin.
- Persistent fatigue.
- Fever.
- Night sweats.
- Shortness of breath.
- Unexplained weight loss.
- Itchy skin.
How big is a cancerous lymph node?
Lymph nodes measuring more than 1 cm in the short axis diameter are considered malignant. However, the size threshold does vary with anatomic site and underlying tumour type; e.g. in rectal cancer, lymph nodes larger than 5 mm are regarded as pathological.
What happens after sentinel lymph node removal?
Lymph node surgery can lead to uncomfortable temporary side effects, such as lymph backup in the armpit, called seroma. Other side effects can linger, including mild armpit discomfort and numbness in the armpit and the upper arm.
What do swollen armpit lymph nodes feel like?
Swollen lymph nodes will feel like soft, round bumps, and they may be the size of a pea or a grape. They might be tender to the touch, which indicates inflammation. In some cases, the lymph nodes will also look larger than usual. Lymph nodes appear in parallel on both sides of the body.
Does removing lymph nodes affect immune system?
Does having lymph nodes removed affect your immune system? Having lymph nodes removed does not affect your body's ability to fight infections. It's common to have lymph nodes under the arm removed as part of surgery for breast cancer.
How do they remove lymph nodes in armpit?
An operation to remove most or all of the lymph nodes under the arm is called an axillary lymph node dissection or axillary clearance. You have a general anaesthetic for this operation. You will be asleep the whole time. The surgeon makes a small cut in your armpit to remove the lymph nodes.